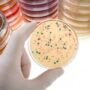
Обнаружены кокки в мазке: что это такое?

Рак поджелудочной железы – это одно из злокачественных новообразований поджелудочной железы, представляющее собой опухолевое разрастание атипичных клеток железистого или плоского эпителия, выстилающего ацинарные элементы или протоковую систему.
Рак поджелудочной железы – это одно из злокачественных новообразований поджелудочной железы, представляющее собой опухолевое разрастание атипичных клеток железистого или плоского эпителия, выстилающего ацинарные элементы или протоковую систему.
Несмотря на достижения современной медицины в диагностике и лечении онкологических заболеваний, рак поджелудочной железы продолжает оставаться одной из нерешенных проблем онкологии. Это связано с особенностями анатомического расположения органа в сочетании с достаточно быстрым развитием и прогрессированием его опухолевой трансформации.
Согласно статистическим данным из разных источников, распространенность рака поджелудочной железы составляет от 9 до 11 случаев на 100 тысяч населения. Преимущественно болеют лица среднего и старшего возраста: от 40 до 75 лет.
Встречаются случаи заболевания и в более молодом и пожилом возрасте. Мужское население болеет почти в два раза чаще, чем женское. Рак поджелудочной железы значительно более распространен в развитых странах Европы, Северной Америки, России, Канады, нежели в Африканских, Южно-Американских и Азиатских странах.
Частота поражения онкологическим процессом разных отделов поджелудочной железы неодинакова. Более чем в 90% случаев диагностируются опухоли с локализацией в головке органа. Оставшиеся 10% равномерно распределены между телом и хвостом поджелудочной железы. Что касается конкретных видов рака, то они зависят от первичного клеточного субстрата опухоли и могут быть такими:
- Протоковая аденокарцинома (встречаемость от 75% до 90%);
- Гигантоклеточная аденокарцинома (распространенность составляет около 6%);
- Железисто-плоскоклеточный рак (регистрируется у 3-4% больных);
- Муцинозная аденокарцинома (встречаемость 1-3%);
- Редкие виды раковых опухолей панкреатических тканей: инсулома, глюкаганома, гастринома (занимают не более 1% в общей статистике).
Большинство случаев рака поджелудочной железы, независимо от гистологического типа и расположения опухолевого очага, диагностируются при достижении ими размера в 4-5 см. А такие параметры характеризуются нарушением структуры органа, прорастанием важных анатомических образований, регионарным и отдаленным метастазированием!
Сколько живут люди с раком поджелудочной железы?
Заболевание относится к разряду серьезнейшей патологии, так как достаточно тяжело поддается диагностике на ранних стадиях развития. Оперативные технологии и химиотерапия, проведенные по радикальной онкологической программе лечения, далеко не всегда хорошо переносятся больными ввиду травматичности и агрессивности по отношению к организму.
Сочетание всех этих факторов сводит к минимуму шансы больных на выживание. Медиана (средний срок) продолжительности жизни среди лиц с установленным раком поджелудочной железы составляет от 6 месяцев до года. Пятилетний рубеж удается пережить не более чем 1-5% больных.
Болезнь, выявленная на ранних стадиях, имеет немного более благоприятные прогнозы, но они мало зависят от своевременности проводимого лечения. Операция ввиду большой сложности часто заканчивается летальным исходом в раннем или позднем послеоперационном периоде.
Такие неутешительные данные возводят рак поджелудочной железы в особый разряд онкологических заболеваний. Ни один другой вид рака не имеет настолько печальной статистики. В последние годы наметилась тенденция к росту заболеваемости при сохранении плохих показателей раннего диагностирования. В 85-90% случаев болезнь обнаруживается на поздних стадиях, когда излечение становится невозможным.
Более ранняя диагностика заболевания затрудняется длительным бессимптомным течением рака и его глубоким расположением с забрюшинной локализацией, что делает его невидимым даже для самых современных методов исследования. Обнаружение рака поджелудочной железы на ранних стадиях часто становится случайной находкой при проведении диагностических процедур по поводу других заболеваний.
Симптомы рака поджелудочной железы
Не смотря на плохие статистические показатели рака поджелудочной железы, ни в коем случае нельзя отказываться от борьбы с ним. Ведь такой путь будет однозначно тупиковым. Ранняя диагностика болезни может помочь больному человеку попасть в те 1-5% пациентов с пятилетней выживаемостью. Ведь встречаются случаи продолжительности жизни после установленного диагноза рака поджелудочной железы и более десяти лет.
Поэтому отчаиваться недопустимо. Обычная настороженность, которая не должна быть маниакальной, в сочетании с внимательным отношением ко всем изменениям, происходящим в организме, помогут выявить болезнь в ранние сроки и предпринять активные меры по борьбе с ней.
К симптомам рака поджелудочной железы относятся:
- Эпигастральная и глубокая боль в пояснице и левом подреберье. Может иметь разную интенсивность. Её появление знаменует прогрессирование болезни. Зависимость прямо пропорциональна: чем интенсивнее болевой синдром, тем тяжелее стадия патологического процесса;
- Потеря аппетита. Возникает практически с первых стадий заболевания и постепенно усиливается;
- Симптомы сахарного диабета – жажда, постоянная сухость во рту, полиурия (увеличение количества суточной мочи). Манифестация рака поджелудочной железы в 15% случаев происходит именно из таких симптомов;
- Частые тромбофлебиты нижних конечностей. Иногда первым проявлением рака поджелудочной железы служит стойкое или рецидивирующее воспаление поверхностных вен нижних конечностей без видимых на то причин (отсутствие варикоза, травм или прочих факторов риска по развитию сосудистой патологии);
- Увеличение живота в размерах. Крайне редко выступает в роли первого признака болезни, но в запущенных случаях возникает всегда. Появление такого симптома связано с метастатическим поражением брюшины (канцероматоз) и скоплением асцитической жидкости в брюшной полости.
Первые признаки рака поджелудочной железы
К ранним признакам можно отнести:
- Вздутие и дискомфорт в области желудка (эпигастральная область). Относится к самым ранним признакам болезни, отмечается более чем у 30% больных;
- Недомогание и немотивированная общая слабость – ещё один ранний симптом болезни в 25% случаев;
- Снижение веса без видимой причины. 98% больных отмечают этот симптом;
- Тошнота с периодической рвотой и другими расстройствами пищеварения. Такой симптом отмечается в 45-50% случаев;
- Желтушность кожи. Один из самых частых и единственных признаков болезни (в 65% случаев) при локализации опухолевого процесса в головке органа. Желтуха носит механический характер, и возникает в результате сдавления общего желчного протока, который проходит в толще панкреатических тканей. Пожелтение кожи может появиться даже при небольших размерах опухоли, пока она ещё не выходит за пределы органа. Но в большинстве случаев наличие первых симптомов болезни в виде желтухи характеризует тяжелые формы рака;
Причины рака поджелудочной железы
Говоря о панкреатическом раке вообще, можно сказать, что это полиэтиологическое заболевание. В роли его причин способно выступать множество разнонаправленных факторов. Какими бы они не оказались, последствия патологического влияния на ткани поджелудочной железы заканчиваются поражением клеточной ДНК.
Как результат – мутация генов эпителиальных, железистых или эндокринных клеток, ответственных за запуск их апоптоза (программированной гибели). В конечном итоге, клетки приобретают аномальные свойства, становятся абсолютно не похожими на здоровые, утрачивают способность выполнять свои функции и начинают бесконтрольно делиться до тех пор, пока жив организм.
Запустить такие мутации генетического клеточного материала способны:
- Хронический панкреатит. Практически у всех больных раком поджелудочной железы в анамнезе имеется это заболевание. Длительное существование воспалительного процесса сопровождается образованием большого количества свободных радикалов и других продуктов перекисного окисления липидов. Накапливаясь в тканях, они способны вызывать повреждение генетического материала тканей поджелудочной железы;
- Генетическая предрасположенность и врожденные мутации генов р53 и K-ras;
- Курение. Замечена связь злостного табакокурения с частотой возникновения раковой трансформации панкреатических клеток;
- Преобладание в рационе мясной пищи на протяжении длительного времени. Такой характер питания отмечают около 80% больных;
- Онкогенные вирусы. Их роль в зарождении мутаций точно не установлена и находится на стадии изучения;
- Химические и физические канцерогены. Они могут поступать в организм из окружающей среды с воздухом, продуктами питания и водой. Как правило, канцерогены представлены пестицидами, гербицидами, частицами бытовой химии, производными бензидина, ионизирующей радиацией и солями тяжелых металлов;
- Влияние алкоголя. Прямой взаимосвязи между раком поджелудочной железы и злоупотреблением алкогольными напитками не установлено. Но если учесть, что алкоголь выступает в роли одного из главных виновников хронического панкреатита, то опосредованное влияние на возникновение ракового поражения панкреатических тканей может считаться вполне доказанным.
Интересный факт. Учеными установлено, что у 95% больных раком поджелудочной железы в желудке присутствует Helicobacter Pilori . Пока её доказана лишь её роль в возникновении язвенной болезни двенадцатиперстной кишки. Но многие крупные медицинские центры продолжают вести исследования в этом направлении.
Остается надеяться, что опыты позволят определить истинную способность этого возбудителя вызывать повреждение ДНК панкреатических клеток.
Степени рака поджелудочной железы
Классификации рака поджелудочной железы по стадиям имеет большое значение. Эти сведения актуальны при определении тактики и плана лечебных мероприятий. Не стоит путать понятие «стадии онкологического процесса» с понятием «клинической группы» заболевания.
Если первое отражает степень поражения и распространенности опухоли, то второе говорит об отношении больного к проведенному лечению. Более актуально рассмотрение стадийности процесса, которое представлено четырьмя степенями.
1 степень. С анатомической и клинической точки зрения первую степень рака поджелудочной железы целесообразно разделять на три вида:
- 0 (нулевая) стадия. Обозначается латинским термином carcinoma in situ. Характеризуется распространением опухоли в пределах базальной мембраны того слоя клеток, из которого она развивается. Такая опухоль не вызывает никаких проявлений и структурных перестроек органа, и не способна к метастазированию;
- 1А стадия. Опухоль прорастает базальную мембрану и достигает в размерах 2х см;
- 1Б стадия. Размеры опухоли превышают 2 см, но она имеет строго внутриорганное расположение, не прорастает важных анатомических образований и не имеет метастазов.
2 степень. Основой второй стадии рака поджелудочной железы является выход опухолевого очага за пределы органа. Выделяют такие степени второй стадии:
- 2А – первичный опухолевый очаг прорастает жизненно важные анатомические структуры (холедох, двенадцатиперстную кишку, мезентериальные сосуды, клетчатку, связки и т.д.). При этом никаких метастазов не регистрируется;
- 2Б – первичная опухоль либо выходит за пределы, либо остается в толще поджелудочной железы, но при этом имеются метастазы в экстраорганные лимфоузлы первого порядка.
3 степень. В основе этой стадии лежит метастатическое распространение опухоли на регионарные лимфатические узлы второго и третьего порядка. При этом метастазы могут регистрироваться в парааортальных, забрюшинных, а также лимфатических узлах по ходу верхней брыжеечной, воротной, общей печеночной артерий и вен. Сама первичная опухоль при этом выходит далеко за пределы органа, прорастая желудок, двенадцатиперстную кишку и сосуды.
4 степень. Самая тяжелая и безнадежная форма любого рака, в том числе и рака поджелудочной железы. Характеризуется широким распространением первичной опухоли на все близлежащие органы, метастазированием во все лимфатические коллекторы. Самая главная отличительная особенность 4 стадии – метастазы в отдаленных органах (печень, легкие и др.).
Диагностика рака поджелудочной железы
Заподозрить и подтвердить диагноз рака поджелудочной железы не всегда легко. Особенно это актуально в отношении ранних стадий заболевания, когда размеры опухоли не превышают 1-2 см.
Для диагностики используются:
- Ультразвуковое исследование. Его проведение подразумевает осмотр всех органов брюшной полости и забрюшинного пространства. Особенно детальное внимание уделяется поджелудочной железе. Одним из залогов информативности УЗИ в диагностике рака считается строгое соблюдение правил подготовки. Ведь орган расположен достаточно глубоко и плохо поддается изучению из-за скопления газов в поперечной ободочной кишке;
- Томографическое исследование. Из этой группы диагностических методов используются компьютерная и магнитно-резонансная томография (КТ и МРТ). Предпочтение должно отдаваться второму исследованию, так как оно лучше визуализирует мягкотканные структуры, к которым относится поджелудочная железа. Метод на сегодня стал золотым стандартом диагностики ракового поражения на ранних стадиях. Позволяет также определить наличие метастазов в регионарных лимфатических узлах и других органах;
- Анализ крови на онкомаркеры. В основе этого метода диагностики лежит иммунно-гистохимическое определение в крови концентрации специфических белковых молекул и антигенов, которые продуцируются раковыми опухолями поджелудочной железы. К ним относятся онкомаркеры: СА 19-9 и СЕА или раковый эмбриональный антиген. Их нормы устанавливает конкретная лаборатория, проводящая анализ, в зависимости от используемых реактивов. Норма обязательно указывается рядом с результатом полученного показателя;
- ЭРХПГ – сокращенная аббревиатура от полного названия метода эндоскопической ретроградной холангиопанкреатографии. Такой способ диагностики не может установить диагноз рака поджелудочной железы. Но он используется для исключения наличия камней в желчных протоках, которые также могут быть причиной появления механической желтухи. А она относится к одному из главных симптомов ракового процесса в головке органа;
- Биопсия поджелудочной железы. Единственным достоверным способом постановки диагноза рака может быть гистологическое исследование патологически измененного участка. Выполнение такого диагностического приема сопряжено с большим риском и техническими трудностями. Биопсия всегда проводится под визуальным контролем. При этом продвижение тонкой иглы, которой последовательно прокалываются все ткани, контролируется под монитором магнитно-резонансного томографа, ультразвука или диагностической лапароскопической операции. Последний способ наиболее приемлем.
Рак поджелудочной железы с метастазами
Злокачественные новообразования поджелудочной железы характеризуются ранним метастазированием. Это связано с мощным кровоснабжением органа, большим количеством лимфатических протоков и лимфоузлов.
Поэтому даже небольшие опухоли, особенно высокодифференцированные аденокарциномы, потенциально способны метастазировать по таким путям:
- Лимфогенному – в регионарные лимфатические узлы по ходу магистральных артерий, забрюшинной клетчатки и ворот печени;
- Гематогенному – в печень, легкие, кости и позвоночник;
- Смешанному (сочетание гематогенного, лимфогенного и контактного путей) – в брюшину, кишечник, желудок и другие структуры брюшной полости.
Наиболее часто приходится сталкиваться с отдаленными метастазами в печень. Как правило, они постоянно прогрессируют в виде появления новых очагов, которые постоянно увеличиваются в размерах. На четвертой стадии болезни печень таких пациентов резко увеличивается в размерах и приобретает вид опухолевого конгломерата, состоящего из множественных метастатических узлов.
Вторым по частоте видом отдаленных метастазов считается их расположение в брюшине. Такое состояние называют канцероматозом. Метастазы этого типа также склонны к постоянному увеличению численности и роста в месте прикрепления. При этом всегда возникает асцит. Его появление объясняется раздражением брюшины, которая отвечает повышением секреции внутрибрюшной жидкости в сочетании с нарушением её всасывания.
Наличие метастазов рака поджелудочной железы значительно утяжеляет течение болезни и обрекает больного на безысходность в отношении лечения, которое ни при каких условиях не принесет хороших результатов. Метастазы, как и первичная опухоль, требуют значительных жизненных ресурсов организма для своего роста.
На этом фоне прогрессивно снижается уровень белка и гемоглобина в крови, страдает иммунитет и возникает выраженная раковая интоксикация с кахексией больного.
Лечение рака поджелудочной железы
Комплексный лечебный подход при раке поджелудочной железы предполагает:
- Оперативное лечение. Операбельным считается рак 1-2, а в некоторых случаях и 3 стадии, когда удаление опухоли технически выполнимо, а возраст и общее состояние больного позволяет перенести такое травматичное вмешательство.Среди выполняемых операций выделяют:
- ПДР (панкреатодуоденальная резекция в классическом варианте). Показана при локализации рака в головке и приближенных к ней участках тела поджелудочной железы. При этом одновременно производится лимфодиссекция регионарных лимфатических коллекторов. Во время операции удаляются головка и тело поджелудочной железы, двенадцатиперстная кишка, часть холедоха и желудка. После удаления единого блока с лимфоузлами восстанавливается проходимость желудочно-кишечной трубки путем анастомоза. К отключенной по Ру петле тонкой кишки подшиваются холедох и панкреатический проток. Операция крайне травматична, сопровождается большим количеством осложнений и высокой летальностью;
- Резекция хвоста поджелудочной железы. Менее тяжелая операция, чем ПДР. Она выполняется у больных с локализацией опухоли в хвосте органа. Вмешательство предполагает удаление дистальной части поджелудочной железы вместе с селезенкой и лимфатическими узлами;
- Панкреатэктомия и расширенная резекция поджелудочной железы. Первое вмешательство выполняется крайне редко, а второе может предполагать ПДР либо резекцию хвоста в сочетании с резекцией других органов при их прорастании опухолью.
- Химиотерапия. Предполагает введение химиотерапевтических средств, обладающих токсическим действием в отношении опухолевых клеток. Метод часто комбинируют с оперативным лечением или используют в качестве самостоятельного при неоперабельных формах рака.
- Лучевая терапия. В терапии рака поджелудочной железы используется крайне редко. Предполагает целенаправленное чрезкожное подведение к опухоли высоких доз ионизирующего излучения;
- Паллиативное и симптоматическое лечение. Включает в себя оперативные вмешательства, восстанавливающие проходимость желудка, двенадцатиперстной кишки и желчных путей. При этом манипуляции с опухолью не проводятся. Симптоматическая терапия предполагает введение обезболивающих и детоксикационных препаратов.
Питание при раке поджелудочной железы
Особенностям режима питания при раке поджелудочной железы не придается большого значения, так как диета мало помогает в избавлении человека от проблемы. Единственное, что диета действительно позволяет, так это избежать усиления неприятных симптомов расстройств пищеварения, которые часто встречаются при этой патологии.
С одной стороны, пища должна быть достаточно щадящей, чтобы не вызывать стимуляции функционирования измененной поджелудочной железы с усилением болевого синдрома и признаками ферментативной недостаточности. Но с другой стороны, пища должна быть достаточно полезной и питательной, чтобы обеспечить основные жизненные потребности в главных компонентах.
Такой баланс может быть достигнут при помощи соблюдения принципов, приведенных в таблице:
| Тип продуктов | Можно | Нельзя |
| Мясные и рыбные блюда | Сорта мяса диетического типа (индейка, кролик, курица). Нежирная морская и речная рыба. Они не должны быть жирными, и готовятся на пару. | Сорта мяса с высоким содержанием жиров (свинина, говядина, утка, гусь), а также жирной рыбы. Недопустимо употреблять жареные, копченые и приправленные специями блюда. |
| Мучные и хлебобулочные изделия | Хлеб, содержащий отруби и муку грубого помола, простое галетное и овсяное печенье. Выпечка не должна быть очень свежей. | Выпечка из сдобной муки, с высоким содержанием сахара, кремами и шоколадом (булочки, печенье, заварные трубочки). |
| Молочная продукция | Простокваша, кефир, ряженка, йогурт, нежирный творог, плавленый и твердый сыр. | Цельное свежее молоко, жирная сметана |
| Овощи и фрукты | Любые свежие овощные и фруктовые салаты, если их приём не вызывает выраженного вздутия живота и поноса. Салаты приправляются растительными маслами (оливковое, облепиховое, подсолнечное), йогуртом или джемом. Можно включать овощи в состав супов и бульонов, готовить на пару. | Кислые овощи и фрукты концентрированной закваски. Ограничивается употребление томатов и сырой капусты (лучше тушеная). Если на фоне включения в рацион определенных продуктов возникают любое ухудшение состояния, их нужно отменить. |
| Крупы | Рисовая, гречневая, перловая, овсяная каша и пшено. | Бобовые и блюда на основе гороха |
| Прочее | Яйца всмятку, мед, орехи, небольшое количество подсолнечного масла, морсы, чай, отвар из сухофруктов и компот. | Шоколад, кофе, пряности и специи, грибы, алкогольные напитки, газированная вода, особенно содержащая красители. Ограничивается употребление соли и сахара. |
Режим питания больного раком поджелудочной железы должен определяться фактической переносимостью конкретных продуктов. Если у больного возникло желание съесть какое-то блюдо, но оно не входит в список разрешенных, руководствоваться нужно пожеланиями человека. Единственное, что обязательно должно быть соблюдено – это правило постепенного введения продуктов в рацион!
Интересная информация: тимокинон — основное активное вещество, содержащиеся в семенах черного тмина снижает размер опухоли поджелудочной железы в среднем на 67%, и кроме того, значительно снижается уровень цитокинов в опухолях (мощный противоспалительный эффект). Исследования проводились на животных с раком поджелудочной железы в центре Киммеля (США.)
Ориентировочное недельное меню для больного раком поджелудочной железы при пятиразовом режиме питания представлено в виде таблицы:
| День недели | Первый приём пищи | Второй приём пищи | Третий приём пищи | Четвертый приём пищи | Пятый приём пищи |
| Пн. | Кефир и банан | Суп-пюре, чай с хлебом и маслом | Каша с отварной котлетой, овощной салат, компот | Запеканка творожная с какао | Сухари с йогуртом |
| Вт. | Молочная каша с сливочным маслом | Перец фаршированный, чай на основе трав | Суп с крупами на курином бульоне, хлеб | Запеканка фруктово-творожная, какао | Кефир с сухарями |
| Ср. | Кефир, печенье овсяное | Паровые котлеты из рыбы, рисовая каша | Жидкое блюдо из свеклы (борщ), овощной салат, компот | Яблоки, запеченные с киселем | Ряженка с галетным печеньем |
| Чт. | Йогурт с галетным печеньем | Каша гречневая, с овощным салатом, зеленый чай | Пюре картофельное с паровой котлетой, хлеб, кисель | Морковный сок, яичный омлет | Узвар из сухофруктов с мёдом |
| Пт. | Запеченное яблоко, зеленый чай | Овощной суп, хлеб с отрубями | Ячневая каша с маслом, отварной рыбой, овощной салат, компот | Сладкие свежие фрукты, некрепкий чай | Кефир с сухарями |
| Сб. | Творожная запеканка, какао | Крем суп на основе овощей и мяса кролика | Макароны с маслом и докторской колбасой, хлеб, компот | Молочная каша с фруктовым вареньем | Стакан кефира |
| Вс. | Йогурт с галетным печеньем или сухарями | Крем-суп из картофеля, цветной капусты и куриного фарша | Рыбное филе с отварными овощами, узвар из сухофруктов | Банан с творогом | Йогурт с овсяным печеньем |
Приведенное меню не является стандартом, которого нужно строго придерживаться. Оно может видоизменяться в любых направлениях, согласно конкретным предпочтениям больного человека. Количество приемов пищи может быть расширено до 6 и более раз в сутки, если больной в состоянии питаться только небольшими порциями.